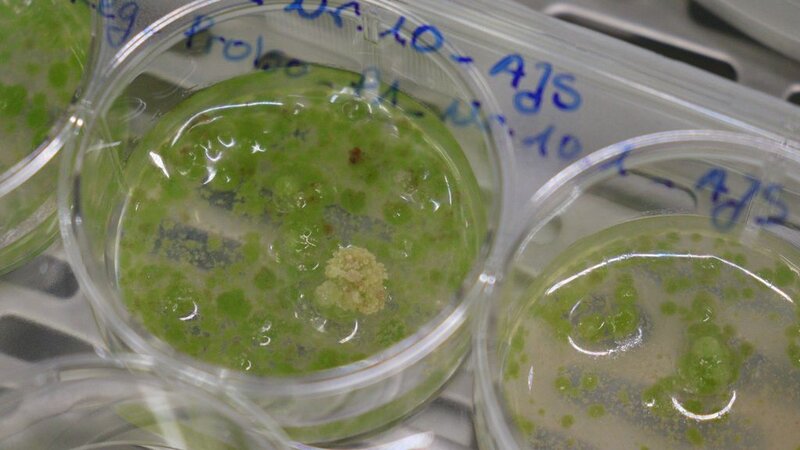

Genetische Technologien
FNR-Nachwuchsforschungsgruppe
Die Gruppe "Genetische Technologien" ist eine eigenständige Nachwuchsforschungsgruppe am Thünen-Institut für Forstgenetik, die durch die Fachagentur Nachwachsende Rohstoffe (FNR) gefördert wird. Sie gehört zum Projekt "TreeEdit".
Wir erforschen die CRISPR/Cas-vermittelte Genomeditierung von Bäumen, insbesondere ob und wie diese Methoden in Gehölzen funktionieren und welche Potenziale und Risiken damit verbunden sind. Damit erweitern wir das Wissen hinsichtlich dieser Technologien in Baumarten, das häufig auf Ergebnissen der Kulturpflanzenforschung basiert.
Neben dieser technologischen Forschung leistet die Gruppe Genetische Technologien bedeutende Forschung im Bereich der Klimaanpassung. Pappeln dienen uns als Modellorganismen, an denen die genetischen Grundlagen von Trockenstresstoleranz erforscht werden. Durch eine experimentelle Veränderung der beteiligten Gene wollen wir Rückschlüsse auf ihre Funktion ziehen. Die Ergebnisse sollen auf die bedeutendste deutsche Laubbaumart, die Rotbuche Fagus sylvatica, übertragen werden.
In einem Teilprojekt untersuchen wir die Genexpression von Rotbuchen unterschiedlicher Herkünfte unter Trockenheitsstress. Damit erhoffen wir uns Erkenntnisse zur natürlichen Stressantwort von Rotbuchen und welche Unterschiede zwischen mittel- und südeuropäischen Rotbuchen bestehen. Mit unseren Partnern verbinden wir genetische, molekulare und physiologische Analysen.
Mitarbeitende
Dr. Tobias Brügmann (Nachwuchsgruppenleiter)
Alexander Fendel (Doktorand)
Virginia Zahn (Doktorandin)
Susanne Jelkmann (Technische Assistentin)
Ian Volkmann (Laborant)
Emily Idahl (Master-Studentin, seit Januar 2025)
Godje Roß (Bachelor-Studentin, seit März 2025)
Amelie Keller (Bachelor-Studentin, seit Mai 2025)
Luisa Bisping (Bachelor-Studentin, seit Mai 2025)
+ ein:e Auszubildende:r in Lab-Rotation
Pappeln unter Trockenstress - oder eben nicht?
Wie reagieren unsere Pappeln auf Trockenheit?
In unserem Forschungsprojekt wollen wir ausgewählte Gene in Pappeln charakterisieren und untersuchen, ob sie an der Trockenstresstoleranz von Bäumen beteiligt sind. Dazu prüfen wir, ob eine gesteigerte Ausprägung eines ausgesuchten Gens oder das Ausschalten des Gens dazu führt, dass Pappeln widerstandsfähiger gegenüber Trockenheit sind.
Unter den kontrollierten Bedingungen im Gewächshaus lassen sich mit invasiven (Blätter werden vom Baum entnommen) und nicht invasiven Methoden (Blätter verbleiben am Baum) viele Messwerte erfassen, mit deren Hilfe die Stressreaktion verfolgt werden kann. Neben physiologischen und morphologischen Analysen im Gewächshaus wird eine Vielzahl von molekularphysiologischen Analysen im Labor durchgeführt. Dort wird insbesondere untersucht, ob die Pflanzen oxidativen Stress hatten, wie hoch ihr Gehalt an Prolin, einem Marker für Stressreaktion, ist und wie viel Abscisinsäure als zentrales Stresshormon gebildet wurde.
An diese Arbeiten angeschlossen sind zwei Masterarbeiten in Kooperation mit den Universitäten in Hannover und Hamburg.
Alexander Fendel und Tobias Brügmann haben die Konzeptionierung und die Auswertung solcher Stressversuche in einem Artikel in der Zeitschrift AFZ-DerWald beschrieben: Fendel A, Brügmann T (2023) Kontrolliert unter Stress. AFZ Der Wald 78(20):12-15.



Stressversuche im Klimawald
Projekt-Baustein
Rotbuchen haben ein großes Verbreitungsgebiet, an dessen südlichem Rand sie mit anderen klimatischen Bedingungen konfrontiert sind als in Deutschland: Die Jahresdurchschnittstemperatur liegt über den deutschen Werten; die Niederschlagsmenge ist geringer als in Deutschland. Zur Untersuchung der unterschiedlichen Trockenstresstoleranz von Buchenherkünften wurde in Berlin ein Herkunftsversuch ("Klimawald") angelegt, in dem einzelne Versuchsglieder (eine Gruppe von Bäumen) bewässert werden können, während andere Versuchsglieder im Sommer vom (natürlicherweise eintretenden) Trockenstress beeinflusst werden. Im Sommer 2022 wurde ein Trockenstressversuch mit jeweils einer Herkunft aus Deutschland, Frankreich, Italien und Spanien initiiert. Dabei wurden nach unterschiedlichen Stressintensitäten ökophysiologische, biochemische und genetische Analysen durchgeführt. Mit den Daten soll die Trockenstresstoleranz einzelner Rotbuchen-Herkünfte abgeschätzt werden.
Die genetischen Regulierungen werden mittels Transkriptomanalyse untersucht. Dazu werden alle mRNA-Moleküle, die in den Blättern gebildet werden, entschlüsselt. Auf biochemischer Ebene werden u.a. die Gehalte der Trockenstressmarker Prolin, Malondialdehyd (MDA) und Peroxid gemessen. Zusammen mit den physiologischen Daten wie der Photosyntheseaktivität, der stomatären Leitfähigkeit und dem Wasserpotenzial soll der analytische Dreiklang ein umfassendes Bild der Trockenstresstoleranz ergeben.
Wir erwarten Antworten auf die Fragen: Welche Reaktion zeigen die Rotbuchen unter Trockenstress? Unterscheiden sich die ausgewählten Herkünfte in ihrer Trockenstressreaktion? Welche Gene werden ein- bzw. ausgeschaltet und wie schnell bzw. wie stark wird die Genaktivität reguliert? Hängt die standortabhängige, unterschiedliche Stresstoleranz mit einer unterschiedlichen Genregulation zusammen? Die Erkenntnisse aus dieser kooperativen Forschungsarbeit können bei der Auswahl von geeigneten trockentoleranten Herkünften hilfreich sein.
Herkünfte der Versuchsbäume
Kooperationspartner
AG Ökologie der Pflanzen, Freie Universität Berlin (PD Dr. M. Forstreuter)
AG Pflanzenbiotechnologie und Bioinformatik, Technische Universität Braunschweig (Prof. Dr. B. Pucker)
Neuigkeiten aus der Nachwuchsforschungsgruppe

Die Rotbuche ist die wichtigste Laubbaumart in Deutschland. Neue Protokolle ermöglichen die Etablierung von Rotbuchen in der In-vitro-Kultur für die vegetative Vermehrung und biotechnologische Forschung.
Die Rotbuche hat eine große ökologische und wirtschaftliche Bedeutung in Mitteleuropa, ist jedoch zunehmend durch Klimawandel und Trockenheit bedroht. Die Anpassung der Baumart ist aufgrund ihrer langen Generationsdauer erschwert.
Unsere Ergebnisse zur Etablierung von In-vitro-Kulturen der Rotbuche wurden nun im Fachmagazin „Plant Methods“ veröffentlicht. In der Studie wurden Zweige von Buchen aus dem Berliner Grunewald und Sämlinge aus Deutschland verwendet. 13 von 22 Herkünften konnten erfolgreich in vitro etabliert werden. Intensive Sterilisierungsprozesse und Antibiotika halfen gegen bakterielle und pilzliche Kontaminationen.
Die Publikation wurde im Rahmen des Projekts TreeEdit erstellt, das vom Bundesministerium für Ernährung und Landwirtschaft über die Fachagentur Nachwachsende Rohstoffe (FNR) gefördert wird.
Originaltitel: „Benefiting from the past – establishing in vitro culture of European beech (Fagus sylvatica L.) from provenance trial trees and seedlings“ (Zahn et al., 2025, Plant Methods 21.1:31).
Das Thünen-Institut für Forstgenetik war in diesem Jahr in der Halle des Bundesministeriums für Ernährung und Landwirtschaft (BMEL) auf der Grünen Woche vertreten. Die Grüne Woche gilt als die international wichtigste Messe rund um Ernährung und Landwirtschaft. Auch Wald-Aspekte werden auf der Grünen Woche aufgegriffen.
Am Stand der Forstgenetik war zentrales Element ein Stressversuch mit Pappeln, die aus der Gewebekultur in Pflanztöpfe überführt wurden. Dieser Versuch stellte anschaulich die Forschungsarbeiten unserer Nachwuchsforschungsgruppe, insbesondere von Doktorand Alexander Fendel, dar. Viele Besucherinnen und Besucher mit und ohne fachlichem Hintergrundwissen waren an dem Aufbau interessiert.
Begleitet wurde der Aufbau mit den Fachinformationen, die hier zu finden sind, darunter auch eine Publikation zur Durchführung der Stressversuche.
Film zum Versuch
In dem Kurzfilm (ohne Ton) zeigen Alexander Fendel und das Team "Genetische Technologien" die Phänotypisierung eines Trockenstressversuchs im Gewächshaus. Darüber hinaus wird die Entnahme von Blattmaterial zur molekular physiologischen Untersuchung im Labor gezeigt und diese exemplarisch anhand einer Methode erläutert.
Wo ins Jahr werden wissenschaftliche Tagungen am besten hingelegt? Am besten innerhalb der vorlesungsfreien Zeit, damit Uni-Beschäftigte auch problemlos daran teilnehmen können. Und dann am besten nicht genau in die hochsommerliche Urlaubszeit. Daher ist häufig der September mit vielen Tagungen gespickt. Unsere Gruppe war bei zwei Tagungen vertreten:
Forstgenetische Diskussionen in Freiburg
Vom 11. bis zum 13. September 2024 fand in Freiburg die Sektionstagung Forstgenetik und Forstpflanzenzüchtung des DVFFA (Deutscher Verband forstlicher Forschungsanstalten) statt. Diese Tagung, mit dem Thünen-Institut für Forstgenetik als Mit-Ausrichter, ist ein Highlight, da Forschende unterschiedlicher Ausrichtungen und Leute aus der Forstpraxis zusammenkommen und sich austauschen können.
Alexander Fendel hielt einen Vortrag über die Analyse der Trockenstresstoleranz von Pappeln, in denen bestimmte Gene modifiziert wurden. Dadurch lassen sich Rückschlüsse auf die Bedeutung dieser Gene für die Klimawandelanpassung von Bäumen gewinnen. Auf der Tagung tauschten sich Alexander und Kolleg:innen insbesondere über das sogenannte Phenotyping aus, also wie die Bäume im Gewächshaus untersucht werden, welche Parameter erhoben werden und wie diese Daten zu interpretieren sind.
Tobias Brügmann hielt einen Vortrag über die biotechnologische Forschung an Bäumen. Hierbei ging es vor allem um die Übertragung des Wissens aus den letzten Jahrzehnten, das vor allem mit schnellwachsenden Baumarten wie Pappeln gewonnen wurde, auf die Rotbuche. So berichtete er von den Forschungsarbeiten der Doktorandin Virginia Zahn, die eine Gewebekultur für die Rotbuche und weitere biotechnologische Prozesse etablierte.
Den Abschluss der Tagung bildete eine Exkursion. Hier gab es nochmal Gelegenheit zum Austausch über die Herausforderungen des Waldes.
Botanische Grundlagenforschung in Halle/Saale
Die zweijährlich stattfindende Botaniktagung wurde in diesem Jahr vom 15. bis zum 19. September in Halle an der Saale ausgerichtet. In diesem Riesen-Event mit drei zeitgleichen Vortrag-Sessions und hunderten Posterpräsentationen lassen sich wesentliche Eindrücke der Grundlagenforschung und neuer Methoden gewinnen. Der Austausch mit den Kolleginnen und Kollegen sorgt für neue Inspirationen für die eigene Projektarbeit. Ein eigener Bericht zur Botaniktagung ist hier zu finden.
Vom 23. bis 29. September fand in der schwedischen Hauptstadt Stockholm der IUFRO Weltkongress statt. Alle vier Jahre kommen bei diesem Kongress die internationalen Wald-Forschenden zusammen, zusätzlich Vertreterinnen und Vertreter aus Politik, Medien und forstlicher Praxis, um die aktuellen Herausforderungen zu diskutieren. Die Eröffnung durch den schwedischen König, seiner Majestät König Carl XVI. Gustaf, unterstrich die Bedeutung dieser Veranstaltung, die dieses Jahr unter dem Motto "Forests and Society towards 2050" stand.
Vom Thünen-Institut für Forstgenetik war neben Katharina Liepe und Niels Müller auch Tobias Brügmann anwesend. In seinem Vortrag "Elucidating the effect of single gene modifications on drought stress tolerance of poplars (Populus)" berichtete Tobias über Ergebnisse aus den aktuellen Versuchen der Nachwuchsforschungsgruppe.
Persönliches Highlight war die Begegnung und das Gespräch mit einem DER deutschen Klimawissenschaftler, Prof. Hans Joachim Schellnhuber. Schellnhuber war Gründungsdirektor des Potsdam-Instituts für Klimafolgenforschung und Mitglied des Weltklimarats IPCC.
Im Mai haben wir Matthias Fladung, den bisherigen Leiter des Arbeitsbereichs Genomforschung, in den Ruhestand verabschiedet. Matthias fungierte auch für das Drittmittelprojekt "TreeEdit" hinter der Nachwuchsforschungsgruppe als Projektleiter. Für sein großes Engagement und gute Impulse sind wir ihm sehr dankbar!
Die TreeEdit-Projektleitung hat der Tobias Brügmann, Leiter der Nachwuchsforschungsgruppe, übernommen. Neuer Arbeitsbereichsleiter Genomforschung wird Niels Müller, der bislang schon als wissenschaftlicher Mitarbeiter im Arbeitsbereich tätig war. Wir freuen uns auf die Zusammenarbeit!
Anfang März erhielten wir die langersehnte Nachricht des Projektträgers FNR: Die Arbeiten der Nachwuchsforschungsgruppe Genetische Technologien im Rahmen des Projekts TreeEdit können fortgesetzt werden. Mit großem Elan arbeiten wir jetzt insbesondere verstärkt an finalen Versuchen, Auswertungen und dem Publizieren der Forschungsergebnisse.
Im Jahr 2023 wurde das gesamte Thünen-Institut vom Wissenschaftsrat evaluiert. Sowohl in schriftlichen Berichten als auch persönlichen Präsentationen hat die Nachwuchsgruppe ihre Arbeiten rund um CRISPR/Cas-Genomeditierung und Klimawandelanpassung dem Gremium dargestellt. Im Januar 2024 wurde die lang erwartete Stellungnahme des Wissenschaftsrats veröffentlicht.
Die Nachwuchsgruppe und ihre Arbeiten wurden erfreulich positiv erwähnt:
„Am Fachinstitut für Forstgenetik besteht eine von der Fachagentur für Nachwachsende Rohstoffe geförderte Nachwuchsforschungsgruppe „Genetische Technologien“. Forschungsschwerpunkt ist die CRISPR/Cas-vermittelte Genomeditierung von Bäumen, insbesondere die Frage, ob und wie diese Methoden in Gehölzen funktionieren und welche Potenziale und Risiken damit verbunden sind.“ (Seite 38)
„Besonders zukunftsweisend und vielversprechend sind Arbeiten zur genetischen Anpassung von Bäumen inkl. der Nutzung von CRISPR/Cas zur Überprüfung von Ursache-Wirkung-Beziehungen. Die Arbeiten zur Anpassung von Bäumen sollten weiterverfolgt und zu einem Profilelement des Instituts ausgebaut werden.“ (Seite 69)
Auch die Gesamtevaluierung des Thünen-Instituts für Forstgenetik verlief sehr positiv, sodass der oben verlinkte Bericht unbedingt lesenswert ist.
Aktueller Wissensstand zum Genome Editing in Bäumen & Klimawald-Festakt
Zahlreiche europäische Wissenschaftler:innen haben sich zusammengeschlossen, um in einem Buch den aktuellen Stand zur Genomeditierung von Pflanzen darzustellen. Das Buch "A Roadmap for Plant Genome Editing" informiert über Pflanzenzüchtungstechnologien, Anwendungsgebiete, rechtliche Aspekte und gesellschaftliche Wahrnehmung.
Tobias, Alexander, Virginia und TreeEdit-Projektleiter Matthias haben ein Kapitel über Genome Editing in Bäumen beigesteuert: Genome Editing in Forest Trees. Darin werden die Voraussetzungen für eine Genomeditierung in Bäumen, bereits editierte Baumarten, aktuelle Entwicklungen, relevante Züchtungsmerkmale und Biosicherheitsaspekte beleuchtet.
Klimawald-Festakt am 16. Dezember
Die interessierte Öffentlichkeit über die Forschung zu informieren, ist Bestandteil wissenschaftlicher Arbeit, der immer wichtiger wird. Durch die Wissenschaftskommunikation sollen Forschungsprozesse transparent dargestellt und dafür aufgewendete Finanzmittel gesellschaftlich stärker akzeptiert werden.
Über die Forschung des Thünen-Teams im Klimawald Berlin informierte Tobias viele Gäste, die zum Festakt "75 Jahre Freie Universität Berlin" erschienen waren. Der Universitätspräsident hob die Relevanz von Forschung zu Wald und Forst sowie zu Klimawandelanpassung und Biodiversität in seiner kurzen Festrede hervor. Die Beteiligung der Leiter des Landesforstamts Berlin und des Forstamts Grunewald unterstrich die Verbindung von Wissenschaft und Praxis.


Wie in der Projektausschreibung vorgesehen, wird die Nachwuchsforschungsgruppe nach etwa zweieinhalb Jahren evaluiert. Dafür wurden die fachlichen Ergebnisse, sowie zahlreiche Vorträge, Posterpräsentationen und Veröffentlichungen zusammengetragen. Ausdrückliches Ziel der Mitarbeitenden ist die positive Evaluierung, sodass die Forschung um zwei Jahre bis zum Frühjahr 2026 fortgesetzt werden kann.
Parlamentarischer Abend in Berlin
Am 14. November war Dr. Tobias Brügmann beim parlamentarischen Abend der mathematisch-naturwissenschaftlichen Fachgesellschaften dazu eingeladen, mit Bundestagsabgeordneten und deren Mitarbeitenden über seine Forschungsthemen zu diskutieren. Ein Bericht zu dieser Veranstaltung ist hier online!
Im Rahmen der EU COST-Action "PlantEd" hatten die beiden Doktorand:innen Virginia und Alexander erstmals die Möglichkeit, eine internationale Tagung im Ausland zu besuchen. Bei der Veranstaltung in Porto (Portugal) stellten sie ihre Arbeiten und Ergebnisse im Projekt TreeEdit den Fachkolleg:innen vor. Durch den Austausch sammelten die Thünen-Forschenden auch Anregungen für ihre eigene, weitere Arbeit.
Die bisherigen Projektergebnisse wurden von Gruppenleiter Tobias bei weiteren Tagungen vorgestellt, die sich an unterschiedliche Publikumsgruppen richteten:
Vom 11. bis 13. September fand die Forstwissenschaftliche Tagung in Dresden statt, die neben Forschenden aus den Bereichen der Forstwissenschaften, Forsttechnik, Forstgenetik und weiterer Fachrichtungen auch speziell für Anwender:innen interessant war, darunter Förster:innen, Waldbesitzer:innen und Forstpflanzenzüchter:innen. Tobias berichtete in einem Vortrag über das "Teilprojekt Klimawald" und mit einem Poster über biotechnologische Forschung mit Bäumen.
Am 25. September lud die Gesellschaft für Pflanzenbiotechnologie zu einer Tagung ein, die sich an die Fachleute in diesem Gebiet richtete. Hier stellte Tobias in einem Vortrag die Forschungsarbeiten zur Trockenstresstoleranz von Pappeln dar, die im Projekt als Modellorganismen genutzt werden.

Gleich zwei Studierende haben ihre Bachelorarbeiten abgeschlossen:
Keelin Meyer von der Hochschule Emden-Leer hat mit ihrer Bachelorarbeit zur Agrobacterium-vermittelten Transformation der Rotbuche den letzten Baustein ihres Biotechnologie-Studiums abgeschlossen. Diese Arbeit fand in Kooperation mit Prof. Dr. G. Kauer statt.
Alina Fomin konnte ihre Abschlussarbeit einreichen, die vor allem biochemische Analysen von Stressmarkern beinhaltete. Ihre Analysen von Prolin, MDA und Wasserstoffperoxid in Rotbuchen-Blättern leisteten einen Beitrag zum "Klimawald-Versuch", der in Kooperation mit der Freien Universität Berlin und der Technischen Universität Braunschweig durchgeführt wird. Alina hat damit ihr Studium an der Universität Lübeck abgeschlossen, wo das Gutachten Prof. Dr. L. Redecke übernahm.
Im Mai 2023 hat unsere Forschungsgruppe eine Wissenschaftsredakteurin der Frankfurter Allgemeinen Zeitung (FAZ) besucht. Sie hat sich dabei vor allem für unsere Ansätze interessiert, die die CRISPR/Cas-vermittelte Genomeditierung als Werkzeug verwenden, um Gene zur Charakterisierung auszuschalten. Mit diesen Pflanzen führen wir Stressversuche im Gewächshaus durch. Daraus erhoffen wir uns Erkenntnisse über die Funktion der Zielgene, um sie im Züchtungsprozess zu berücksichtigen. Diese Forschungsarbeiten finden im Rahmen der Klimawandelanpassung von Bäumen statt: Anhand von Pappeln als Modellorganismen untersuchen wir, welche Gene an der Trockenstresstoleranz von Bäumen beteiligt sind.
Der Bericht der FAZ ist mit vielen Fotos und Illustrationen online zu lesen.
Am 17. und 18. April 2023 fand die erste CopyTree-Tagung in Santiago de Compostela (Spanien) statt. CopyTree ist eine Forschungsinitiative der EU (COST-Action), die europäische Forschende im Bereich der Biotechnologie mit Bäumen und Gehölzen zusammenführen soll.
Die Konferenz mit dem Titel „Innovative Woody Plant Cloning“ widmete sich vielen wichtigen Fragestellungen. Dr. Tobias Brügmann eröffnete die sogenannte Plenary Session mit einem Vortrag über die biotechnologische Forschung in Forstgehölzen, wie Pappeln, Rotbuchen, Eiche und dem invasiven Asiatischen Götterbaum.
Am 28. November 2022 war Tobias Brügmann eingeladen, einen Vortrag im Seminar "Angewandte Gehölzökologie" an der Freien Universität Berlin zu halten. Auf Einladung von PD Dr. Manfred Forstreuter diskutierte er zunächst mit Studierenden die Forschung an Rotbuchen im Klimawald Berlin und stellte die nächsten Schritte im Projekt vor. Anschließend waren zu einem öffentlichen Vortrag rund 40 Teilnehmende aus Wissenschaft und Praxis erschienen. Manfred Forstreuter fasste zusammen: "Vom Genetik-Professor bis zum Forst-Studenten." Diesem Publikum erklärte Tobias Brügmann, welche Projektziele seine Nachwuchsforschungsgruppe verfolgt und ging insbesondere auf die Transkriptomanalyse der Bäume vom Klimawald ein. In der anschließenden Diskussion wurden Aspekte aus der molekularbiologischen Forschung und der Forstpraxis ausgetauscht. Über die Frage "Wie können die Forschungsergebnisse zur Klimawandelanpassung von Bäumen und Wäldern beitragen?" tauschte sich das Plenum angeregt aus.
Die nächste Gelegenheit zur Diskussion am 29. November: Ins Tagungszentrum der Bundespressekonferenz in Berlin hatte unter anderem der VBIO Politiker:innen sowie Vertreter:innen der Wissenschaftsorganisationen, wie Leopoldina, eingeladen, um über Genomeditierung in der Pflanzenforschung zu informieren, zu diskutieren und Fragen zu beantworten. Dr. Tobias Brügmann war im Expertenpanel neben Prof. Holger Puchta (KIT), Prof. Stephan Clemens (Uni Bayreuth) und Dr. Jana Streubel (Uni Hannover). Für die Bundestagsabgeordneten war insbesondere im Lichte der beabsichtigten Novellierung europäischer Vorschriften das "Ohr an der Wissenschaft" wichtig. Im zweiten Veranstaltungsteil trafen sich die Experten mit Medienvertretern, um sich auch hier über Genomeditierung auszutauschen.

In einer Kooperation mit der Freien Universität Berlin (PD Dr. Manfred Forstreuter) und der Universität Concepción (Chile, Dr. Sofia Valenzuela) wurden aus dem Klimawald 64 Rotbuchen ausgewählt, die genetisch und biochemisch von uns untersucht werden (siehe Juli 2022). Die biochemischen Analysen übernimmt die neue Bachelorandin Alina Fomin von der Universität Lübeck, die im November 2022 ihre Abschlussarbeit bei uns begonnen hat. Unter der Anleitung von Alexander Fendel werden u.a. die Gehalte an Prolin, Malondialdehyd (MDA) und Peroxiden ermittelt. Mit diesen Daten soll ermittelt werden, ob Rotbuchen aus Deutschland, Spanien, Frankreich oder Süditalien unterschiedlich stark unter Stress leiden, wenn sie einen Wassermangel erfahren.
Parallel dazu wird von Susanne Jelkmann die RNA von den 64 ausgewählten Bäumen isoliert, sodass in Kürze die RNA-Sequenzierung starten kann. Alexander Fendel und Tobias Brügmann stehen in regelmäßigem Austausch mit den Berliner Projektpartnern. Das Team um Manfred Forstreuter und seine Bachelorandin Maike Woith wertet die physiologischen Daten aus, die direkt auf der Fläche erhoben wurden. Im weiteren Verlauf sollen die Daten von Physiologie, Biochemie und Genetik zusammengeführt werden, um die Trockenstresstoleranz einzelner Rotbuchen-Herkünfte abschätzen zu können.
Nach den vielen Veranstaltungen im September stand im Oktober wieder die praktische Laborarbeit im Fokus des Teams. Unterstützt wird das Team seit dem 24. Oktober von Keelin Meyer, die als Bachelorandin ihre Abschlussarbeit im Großhansdorfer Thünen-Institut absolviert. Unter der Anleitung von Virginia Zahn wird Keelin versuchen, ein in planta-Transformationssystem für Rotbuchen zu entwickeln. Das würde für die Genomeditierung ein großes Hindernis überwinden, da die bislang zur genetischen Transformation benötigte in vitro-Kultivierung von Rotbuchen äußerst schwierig ist. Der hochschulseitige Co-Betreuer dieser Arbeit ist Prof. Dr. Gerhard Kauer von der Hochschule Emden-Leer.
Tobias Brügmann hatte zu Beginn Monats einen Austausch mit der Landwirtschaftlichen Rentenbank: Die Gesprächspartner:innen aus Vorstand und der forstlichen Abteilung waren daran interessiert, was Forschende im Forstbereich beschäftigt. Tobias stellte die Forschungsgebiete des Teams in der Nachwuchsforschungsgruppe dar und wies auf die drängenden Herausforderungen des Klimawandels hin. Die Teilnehmenden waren sich einig, dass man im guten Austausch bleiben wird.
"Botanik-Tagung" der Deutschen Botanischen Gesellschaft in Bonn
Die eigenen Forschungsprojekte auf Konferenzen zu präsentieren und mit Fachleuten zu diskutieren, gehört zu einer der Kernaufgaben für Forschende. Virginia, Alexander und Tobias haben von Ende August bis Mitte September einen wahren Konferenzmarathon hingelegt:
Bei der Botanik-Tagung vom 28. August bis zum 1. September 2022 in Bonn schnupperten Virginia und Alexander erste "internationale Tagungsluft", auf die pandemiebedingt länger gewartet werden musste. Insgesamt mit zwei Vorträgen und zwei Postern war unsere Forschungsgruppe vertreten.
"PlantEd Meeting" der EU-COST Action PlantEd in Düsseldorf
Erfreuliches Ende der Tagung vom 5. bis zum 7. September: Das Poster von Tobias mit dem Titel "On track towards DNA-free genome editing", das über die gemeinsamen Forschungen mit Gastwissenschaftler Stefano Biricolti, Matthias Fladung und Dirk Becker von der Universität Hamburg berichtet, kam sehr gut bei den Tagungsbesuchern an. Tobias wurde dafür mit einem von drei Posterpreisen der Tagung ausgezeichnet.
"Sektionstagung Forstgenetik/Forstpflanzenzüchtung" der DVFFA in Ahrensburg
Eine forstlich orientiere Tagung haben wir vom 12. bis zum 14. September besucht. Gleich den ersten Vortrag des Tages durfte Tobias halten mit einer ausführlichen Übersicht: Der Vortrag "Neue biotechnologische Methoden für Gehölze" gab einen Überblick über die Nobelpreis-ausgezeichnete CRISPR/Cas-Technik und Forschungsstand in Gehölzen. Anschließend berichtete Virginia über ihre bislang erfolgreichen Arbeiten zur Etablierung einer stabilen in vitro-Kultur der Rotbuche (Fagus sylvatica), die ein Grundstein für die weitere molekularbiologische Bearbeitung bilden soll. Alexander stellte Züchtungsmethoden dar, die in einjährigen Kulturpflanzen bereits gut etabliert sind, aber bislang kaum Einfluss in die Forstpflanzenzüchtung gefunden haben. Auch wenn das noch als Zukunftsmusik verstanden werden darf, zeigte er auf, wie ein präziser Züchtungansatz auf die Trockenstresstoleranz von Bäumen wirken kann.
Wie unterscheidet sich die natürliche Stressantwort von Rotbuchen verschiedener Herkünfte unter Trockenstress?
Rotbuchen (Fagus sylvatica) haben ein großes Verbreitungsgebiet. In Mitteleuropa ist die Rotbuche die häufigste Laubbaumart. Am südlichen Rand des Verbreitungsgebiets, in Nordspanien, Südfrankreich und Süditalien, sind Rotbuchen mit anderen klimatischen Bedingungen konfrontiert: Die Jahresdurchschnittstemperatur liegt über den deutschen Werten; die Niederschlagsmenge ist geringer als in Deutschland. Und dennoch können in diesen sehr unterschiedlichen Habitaten Rotbuchen wachsen. Daher fragen wir uns:
Werden Gene in Rotbuchen aus Süditalien schneller eingeschaltet als in Rotbuchen aus Mitteleuropa?
Ist zwar die genetische Grundausstattung vergleichbar, aber die Regulation ausschlaggebend?
Ein Team um den Gehölzphysiologen PD Dr. Manfred Forstreuter (Freie Universität Berlin) hat im Berliner Grunewald einen "Klimawald" angelegt, in dem Rotbuchen von unterschiedlichen Herkünften gepflanzt wurden. In einem weltweit einzigartigen Versuchsdesign wurden Wasserleitungen auf dieser Buchen-Versuchsfläche verlegt, sodass einzelne Versuchsglieder (eine Gruppe von Bäumen) bewässert werden können, während andere Versuchsglieder im Sommer vom (natürlicherweise eintretenden) Trockenstress beeinflusst werden.
Expressionsanalysen
Wir beernten die Bäume verschiedener Herkünfte bei unterschiedlich starken Stressbedingungen. Anschließend steht eine Expressionsanalyse an: Zusammen mit Forschenden der Universität Concepción (Chile) möchten wir aufklären, welche Gene "den Unterschied machen". Dazu untersuchen wir gemeinsam mit dem Team von Dr. Sofia Valenzuela die gesamten mRNA-Moleküle, die in den Blättern gebildet werden.
Anhand der Ergebnisse kann geklärt werden:
- Welche natürliche Reaktion zeigen die Rotbuchen unter Trockenstress: Welche Gene werden ein- bzw. ausgeschaltet?
- Wie schnell reagieren die Rotbuchen auf den Trockenstress: Wie schnell und wie stark wird die Genexpression reguliert?
- Hängt die standortabhängige, unterschiedliche Stresstoleranz mit einer unterschiedlichen Genregulation zusammen: Werden Gene in norddeutschen und süditalienischen Rotbuchen unterschiedlich exprimiert?
Durch die Ergebnissen erhoffen wir uns Einblicke in Stressantwort unter naturnahen Bedingungen - ein Vorteil des Freilandversuchs. Die als relevant identifizierten Gene können einerseits im Züchtungsprozess berücksichtigt werden als auch in natürlichen Buchenbeständen untersucht werden, um geeignetes Vermehrungsgut zu verwenden, das besser an Trockenstress und somit den Klimawandel angepasst ist.
Willkommen, Stefano! Seit Anfang Juni haben wir mit Prof. Stefano Biricolti einen Gastwissenschaftler in unserer Forschungsgruppe. Der Biologe aus Florenz unterstützt uns bei der Erforschung neuer Editierungsmechanismen.
Gratulation, Thalia! Unsere Bachelorandin Thalia von Nethen hat im Juni ihre Abschlussarbeit "Promotortests in Nicotiana benthamiana zur Optimierung der Effizienz von CRISPR/Cas-vermittelter Genomeditierung" erfolgreich verteidigt und damit ihr Biotechnologie-Studium an der Hochschule Emden-Leer abgeschlossen. Vereinfacht haben wir im Projekt von dieser Bachelorarbeit profitiert, indem Thalia u.a. unterschiedliche Promotorkonstrukte kloniert und getestet hat, mit denen wir die Genomeditierung antreiben wollen.
Die FNR-Nachwuchsforschungsgruppe enthält ausdrücklich, so die Richtlinie der Förderinitiative und die Projektgenehmigung, die Beteiligung an der Ausbildung wissenschaftlichen Nachwuchses. Dazu gehört einerseits das Promotionsvorhaben der beiden wissenschaftlichen Angestellten sowie die Übernahme universitärer Lehrveranstaltungen durch den Gruppenleiter. Im April 2022 geht's los: Tobias Brügmann ist im Bachelor-Praktikum Genetik und Molekularbiologie der Universität Hamburg beteiligt.
Ein kleiner fachlicher Einblick vom Februar: Viele Literaturberichte und persönliche Erfahrungen haben uns dazu bewogen, uns einen Ruby-exprimierenden Vektor zuzulegen. Ruby ist ein pink-roter Farbstoff, der von Pflanzenzellen produziert werden kann, sobald das Gen dafür übertragen ist. Wir nutzen Ruby als optischen Marker, um einfach zu erkennen, ob neue Transformationsmethoden funktioniert haben. Unsere "Chef-Kloniererin" Virginia hat schnell einige Umklonierungen durchgeführt, sodass wir das System nun in unterschiedlichen Ansätzen nutzen können.
Derweil ist Alexander dabei, unterschiedliche Trockenstressexperimente im Gewächshaus durchzuführen und - fast noch wichtiger - passende invasive und nicht-invasive Analysemethoden in unserem Labor zu etablieren. Schon mal vom DAB Staining gehört? Mit dieser Methode lässt sich oxidativer Stress in Blättern sehr anschaulich feststellen: Nach Behandlung mit DAB färben sich gestresste Bereiche der Pappelblätter braun.
Im Januar haben wir uns für das neue Jahr aufgestellt: Bei einem Projekttreffen haben wir uns einen Überblick über unseren Forschungsstand verschafft, Herausforderungen und Ergebnisse diskutiert und Pläne für die Zukunft geschmiedet. Als exzellente wissenschaftliche Berater waren PD Dr. Matthias Fladung und Dr. Niels Müller aus der Forstgenetik und Dr. Götz Hensel von der HHU Düsseldorf beteiligt.
Mit Inka Stange von der CAU Kiel haben wir eine zweite Bachelorandin in der Forschungsgruppe, die von Alexander mit einem Thema zur Trockenstresstoleranz von Pappeln betreut wird. Zudem haben wir Unterstützung einer BTA-Auszubildenden erhalten: Rose Becker arbeitet bei uns mit bis zum April 2022.
In der ARTE-Reportage "42 - Die Antwort auf fast alles" hat Tobias Brügmann einige Ansätze unserer Forschungsarbeit dargestellt. Das Video der Folge "Wie retten wir die Bäume?", auch mit der Thünen-Kollegin Hilke Schröder, ist in der Mediathek zu sehen: Hier ansehen!
Eine neue Bachelorandin hat in unserer Forschungsgruppe angefangen: Thalia von Nethen von der Hochschule Emden-Leer wird in den nächsten Monaten ein spannendes Thema bearbeiten. Bei ihr wird es um DNA-freie Genomeditierungsmethoden gehen. Mit diesem Thema schließt sie an die Arbeiten aus dem abgeschlossenen Drittmittelprojekt "aProPop" an.
Im Laborjournal (Seite 24) ist ein Interview mit Gruppenleiter Tobias zu finden.
Mit gleich drei Personen haben wir an der Sektionstagung der Gesellschaft für Pflanzenzüchtung in Geisenheim teilgenommen. Virginia und Alexander haben in einem Vortrag die Ziele ihrer Arbeiten dargestellt. Tobias hat einen umfassenden Überblick über den Stand der Genomeditierung in Bäumen gegeben.
Studium, Ausbildung und wissenschaftliche Gäste
Bei uns können Bachelor- und Masterarbeiten sowie Uni-Praktika absolviert werden. Ferner beteiligen wir uns an der Ausbildung von Biologisch-Technischen Assistent:innen. Die Auszubildenden sind in viermonatigen Blöcken in unserem Forschungsbetrieb eingebunden. Bei Interesse oder Fragen hierzu wenden Sie sich bitte an den Tobias Brügmann.
Felix Wiedemann (2024): Masterand, Studiengang Biotechnologie, Universität Hannover
Charakterisierung von PcP5Cs1-Überexpressionslinien in Populus x canescens unter kontrollierten Trockenstressbedingungen
Dr. Anke Bollen (2024): Masterandin, Studiengang Angewandte Umweltwissenschaften, Universität Koblenz
Masterarbeit: Infiltration rekombinanter Ribonukleotidproteinkomplexe (RNP) zur DNA-freien Genomeditierung an Pflanzen als unterstützende Maßnahme zum Erhalt der Biodiversität
Yuna Hartschen (2024): Studentische Praktikantin, Universität Düsseldorf
Ina Martini (2023): Bachelorandin, Studiengang Biotechnologie, Hochschule Emden-Leer
Bachelorarbeit: Etablierung der Fluoreszenzmarker-basierten Effizienzbestimmung modifizierter guide-RNAs in Pappelprotoplasten [mit SpCas9 und Lb-ttCas12a]
Alina Fomin (2023): Bachelorandin, Studiengang Biochemie, Universität Lübeck
Bachelorarbeit: Biochemical analyses of drought stress-related markers and promoter analysis of P5CS1 in European beech (Fagus sylvatica) of different provenances
Keelin Meyer (2023): Bachelorandin, Studiengang Biotechnologie, Hochschule Emden-Leer
Bachelorarbeit: Agrobakterium-vermittelte Transformation der Europäischen Buche (Fagus sylvatica)
Franziska Brunozzi (2023): Studentische Praktikantin, TU München
Prof. Dr. Stefano Biricolti (2022): Gastwissenschaftler aus Florenz/Italien
Thalia von Nethen (2022): Bachelorandin, Studiengang Biotechnologie, Hochschule Emden-Leer
Bachelorarbeit: Promotor-Tests in Nicotiana benthamiana zur Optimierung der Effizienz von CRISPR/Cas-vermittelter Genomeditierung
Stefan Zebbedies (2021): Bachelorand, Hochschule Hannover
Bachelorarbeit: Etablierung der Nickase-Genomeditierung in Pappeln
Oliver Sulkowski (2020) Bachelorand, Biotechnologie, Hochschule Emden-Leer
Bachelorarbeit: Molekularbiologische Untersuchung auf erhöhte Salz- und Trockenstresstoleranz in SCL4- und SCL7-überexprimierenden Pappelhybriden (Populus × canescens).
Kooperationen
Die Forschungsgruppe interagiert mit Wissenschaftler:innen mehrerer Forschungsinstitutionen. Dies sind insbesondere:
Thünen-Institut für Forstgenetik
- Genomforschung am Thünen-Institut für Forstgenetik (Dr. N. Müller)
- Resistenzforschung am Thünen-Institut für Forstgenetik (Dr. B. Bubner)
Nationale Kooperationen
- AG Ökologie der Pflanzen, Freie Universität Berlin (PD Dr. M. Forstreuter)
- AG Molekulare Pflanzengenetik, Universität Hamburg (Dr. D. Becker + Prof. Dr. J. Kehr)
- AG Pflanzenbiotechnologie und Bioinformatik, Technische Universität Braunschweig (Prof. Dr. B. Pucker)
- AG Ökophysiologie, Universität Bonn (Prof. Dr. L. Schreiber)
- Institut für Holzwissenschaften, Universität Hamburg (Prof. Dr. A. Krause + Prof. Dr. L. Hesse)
- AG Biochemie sekundärer pflanzlicher Inhaltsstoffe, Leibniz-Universität Hannover (Prof. Dr. J. Franke)
- Centre for Plant Genome Engineering, Heinrich-Heine-Universität Düsseldorf (Dr. G. Hensel)
Internationale Kooperationen
- Instytut Dendrologii Polskiej Akademii Nauk, Kornik, Polen (Prof. P. Chmielarz)
- Universität Concepción, Chile (Dr. Sofia Valenzuela)
- Universität Novi Sad, Bosnien-Herzegowina (Dr. V. Galovic)
Veröffentlichungen
- 0
Zahn V, Sievers A-J, Kersten B, Fladung M, Brügmann T (2026) First report of genetic transformation and CRISPR/Cas12a-mediated gene editing of European beech (Fagus sylvatica L.) [Preprint]. Cold Spring Harbor: bioRxiv, 31 p, DOI:10.64898/2026.02.06.703565
- 1
Fendel A, Fladung M, Brügmann T (2026) Overexpression of PtaHDG11 enhances drought tolerance and suppresses trichome formation in Populus tremula × Populus alba [Preprint]. Cold Spring Harbor: bioRxiv, 33 p, DOI:10.64898/2026.01.12.699028
- 2
Zahn V, Thiesen FN, Fladung M, Brügmann T (2026) Rotbuchen aus dem Glas. AFZ Der Wald 81(3):32-35
- 3
Zahn V, Fendel A, Sievers A-J, Fladung M, Brügmann T (2025) Benefiting from the past : establishing in vitro culture of European beech (Fagus sylvatica L.) from provenance trial trees and seedlings. Plant Methods 21:31, DOI:10.1186/s13007-025-01350-3
- 4
Brügmann T, Zahn V, Fendel A, Fladung M (2025) Biotechnologische Innovationen an Rotbuchen und weiteren Baumarten. Thünen Rep 119:211-216, DOI:10.3220/253-2025-23
- 5
Wodtke S, Fendel A, Brügmann T (2025) Brush them away : a simple method to remove trichomes and visualize stomata. Mar 24, 2025. Berkeley: protocols io, DOI:10.17504/protocols.io.kxygxwjqwv8j/v1
- 6
Grünhofer P, Herzig L, Zhang Q, Vitt S, Stöcker T, Malkowsky Y, Brügmann T, Fladung M, Schreiber L (2024) Changes in wax composition but not amount enhance cuticular transpiration. Plant Cell Environ 47(1):91-105, DOI:10.1111/pce.14719
- 7
Brügmann T, Fendel A, Zahn V, Fladung M (2024) Genome editing in forest trees. In: Ricroch A, Eriksson D, Miladinovic D, Sweet JB, Laere K van, Wozniak-Gientka E (eds) A roadmap for plant genome editing. Cham: Springer, pp 347-372, DOI:10.1007/978-3-031-46150-7_20
- 8
Brügmann T, Fladung M (2024) Genscheren in der Forstpflanzenzüchtung? AFZ Der Wald 79(5):27-30
- 9
Brügmann T, Orgel F, Jelkmann S, Schröder H (2024) Isolation of high quality RNA from tree leaves using Polyclar in the Spectrum Plant Total RNA Kit. Oct 08, 2024. Berkeley: protocols io, DOI:10.17504/protocols.io.14egn6qkml5d/v1
- 10
Rupps A, Thiesen FN, Raschke J, Walther M, Ehmke E, Safranek L, Eckardt J, Schmidt A, Beck W, Bubner B, Eisold A-ME, Zahn V, Fendel A, Brügmann T (2024) PInK-NET: Resuming the network idea of in vitro tree labs in Germany. In: Sota V, Werbrouck S (eds) In vitro culture of woody crops: problem solving by new approaches : The 2nd Conference of Cost Action CA21157 CopyTree, 22-24 April, 2024, Bulduri Technical School, Jurmala, Latvia ; Book of proceedings. pp 221-230
- 11
Cardi T, Murovec J, Bakhsh A, Boniecka J, Brügmann T, Bull SE, Eeckhaut T, Fladung M, Galovic V, Linkiewicz A, Lukan T, Mafra I, Michalski K, Kavas M, Nicolia A, Nowakowska J, Sagi L, Sarmiento C, Yildirim K, Zlatkovic M, et al (2023) CRISPR/Cas-mediated plant genome editing: outstanding challenges a decade after implementation. Trends Plant Sci 28(10):1144-1165, DOI:10.1016/j.tplants.2023.05.012
- 12
Shahzaib M, Brügmann T, Shakeel M, Khan SH, Azhar MT, Atif RM, Fladung M, Rana IA (2023) Development of climate smart fruit plants via CRISPR/Cas genome editing systems: A spatiotemporal review [Preprint]. 2023051887. Basel: Preprintsorg, 22 p, DOI:10.20944/preprints202305.1887.v1
- 13
Zahn V, Sievers A-J, Fladung M, Brügmann T (2023) Etablierung einer stabilen in vitro-Kultur für Fagus sylvatica - Ein erster Schritt hin zur Genomeditierung in Buchen. Thünen Rep 105:9-10
- 14
Fendel A, Brügmann T (2023) Kontrolliert unter Stress. AFZ Der Wald 78(20):12-15
- 15
Brügmann T, Zahn V, Fendel A, Zebbedies S, Sievers A-J, Becker D, Fladung M (2023) Neue biotechnologische Methoden für Gehölze. Thünen Rep 105:6-8
- 16
Fendel A, Fladung M, Brügmann T (2023) Steigerung der Trockenstresstoleranz in Bäumen durch genetische Modifikationen. Thünen Rep 105:88-89
- 17
Riefler M, Brügmann T, Fladung M, Schmülling T (2022) A constitutively active cytokinin receptor variant increases cambial activity and stem growth in poplar. Int J Mol Sci 23(15):8321, DOI:10.3390/ijms23158321
- 18
Zahn V, Sievers A-J, Fladung M, Brügmann T (2022) A reliable in vitro culture system for Fagus sylvatica - first steps to expend the scope of genome editing in forest trees to beech. In: Plant Sciences for a Sustainable Future : Botanik-Tagung, International Conference of the German Society for Plant Sciences, 2022 Bonn, 28 August - 01 September ; Programme. Deutsche Botanische Gesellschaft, p 249
- 19
Zahn V, Brügmann T, Fladung M (2022) Combining bacterial and viral elements for efficient gene targeting in poplar. In: Plant Sciences for a Sustainable Future : Botanik-Tagung, International Conference of the German Society for Plant Sciences, 2022 Bonn, 28 August - 01 September ; Programme. Deutsche Botanische Gesellschaft, p 85
- 20
Zahn V, Fladung M, Brügmann T (2022) Combining bacterial and viral elements for efficient gene targeting in poplar. In: COST Action CA18111 "Genome Editing in Plants" : Book of Abstracts ; 3rd PlantEd Conference, 5 - 7 September 2022, Düsseldorf, Germany. p 24
- 21
Brügmann T, Zebbedies S, Zahn V, Fladung M (2022) Diverse mutation patterns include large deletions in a CRISPR/nCas9 double nicking approach poplar. In: COST Action CA18111 "Genome Editing in Plants" : Book of Abstracts ; 3rd PlantEd Conference, 5 - 7 September 2022, Düsseldorf, Germany. p 48
- 22
Brügmann T, Zebbedies S, Zahn V, Fladung M (2022) Diverse mutation patterns include large deletions in a CRISPR/nCas9 double nicking approach poplar. In: Plant Sciences for a Sustainable Future : Botanik-Tagung, International Conference of the German Society for Plant Sciences, 2022 Bonn, 28 August - 01 September ; Programme. Deutsche Botanische Gesellschaft, p 248
- 23
Brügmann T, Fladung M, Schröder H (2022) Flexible DNA isolation procedure for different tree species as a convenient lab routine. Silvae Genetica 71:20-30, DOI:10.2478/sg-2022-0003
- 24
Fendel A, Fladung M, Brügmann T (2022) Improvement of drought stress tolerance in poplars (Populus) by modification of candidate genes. In: COST Action CA18111 "Genome Editing in Plants" : Book of Abstracts ; 3rd PlantEd Conference, 5 - 7 September 2022, Düsseldorf, Germany. p 35
- 25
Fendel A, Fladung M, Brügmann T (2022) Improvement of drought stress tolerance in poplars (Populus) by modification of candidate genes. In: Plant Sciences for a Sustainable Future : Botanik-Tagung, International Conference of the German Society for Plant Sciences, 2022 Bonn, 28 August - 01 September ; Programme. Deutsche Botanische Gesellschaft, p 104
- 26
Shrestha A, Fendel A, Nguyen TH, Adebabay A, Kullik AS, Benndorf J, Leon J, Naz AA (2022) Natural diversity uncovers P5CS1 regulation and its role in drought stress tolerance and yield sustainability in barley. Plant Cell Environ 45(12):3523-3536, DOI:10.1111/pce.14445
- 27
Brügmann T, Biricolti S, Becker D, Fladung M (2022) On track towards DNA-free genome editing. In: COST Action CA18111 "Genome Editing in Plants" : Book of Abstracts ; 3rd PlantEd Conference, 5 - 7 September 2022, Düsseldorf, Germany. p 49
- 28
Brügmann T, Deecke K, Fladung M (2019) Evaluating the efficiency of gRNAs in CRISPR/Cas9 mediated genome editing in poplars. Int J Mol Sci 20(15):3623, DOI:10.3390/ijms20153623
- 29
Brügmann T, Fladung M (2019) Genom-Editierung in Bäumen. AFZ Der Wald 74(5):16-18
- 30
Brügmann T, Wetzel H, Hettrich K, Smeds A, Willför S, Kersten B, Fladung M (2019) Knockdown of PCBER1, a gene of neolignan biosynthesis, resulted in increased poplar growth. Planta 249(2):515-525, DOI:10.1007/s00425-018-3021-8
- 31
Brügmann T, Fladung M (2019) Overexpression of both flowering time genes AtSOC1 and SaFUL revealed huge influence onto plant habitus in poplar. Tree Genetics Genomes 15:20, DOI:10.1007/s11295-019-1326-9
- 32
Brügmann T, Polak O, Deecke K, Nietsch J, Fladung M (2019) Poplar transformation. Meth Mol Biol 1864:165-177
- 33
Brügmann T, Fladung M (2016) Flowering time genes influence biomass production in poplars. In: Hensel G (ed) Annual meeting : new breeding technologies in times of politically enforces research prohibition ; German Society of Plant Biotechnology e.V. ; book of abstracts ; Gatersleben, 02.-04.05.2016. Gatersleben: Gesellschaft für Pflanzenbiotechnologie, p 23
- 34
Brügmann T, Polak O, Fladung M (2015) Development and use of novel gene technologies to increase biomass yield in the woody perennial Populus spec. (PopMass) : project A - modification of genes expressed in xylem and flower. In: Conference documents Plant 2040 Status Seminar, March 4 - 6, 2015 in Potsdam. pp 67-68
- 35
Brügmann T, Fladung M (2015) Genetic approaches to increase biomass yield in the woody perennial Populus. In: Vettori C, Vendramin GG, Paffetti D, Travaglini D (eds) IUFRO Tree Biotechnology 2015 Conference : "Forests: the importance to the planet and society" ; 8-12 June 2015, Florence, Italy ; Proceedings. Florenz: IUFRO, pp 507-509
- 36
Schröder H, Brügmann T, Fladung M (2015) Nuclear and chloroplast SNP markers support successful poplar breeding. In: Vettori C, Vendramin GG, Paffetti D, Travaglini D (eds) IUFRO Tree Biotechnology 2015 Conference : "Forests: the importance to the planet and society" ; 8-12 June 2015, Florence, Italy ; Proceedings. Florenz: IUFRO, pp 295-296
- 37
Hönicka H, Fladung M, Lehnhardt D, Brügmann T (2013) Pleiotropic effects of "flowering" genes in transgenic poplar. In: SPP1530 workshop: Pleiotropic effects of flowering time genes and impact on adaptation and speciation, January 21-23,2013, Max Planck Institute for Plant Breeding Research, Köln. p 13
- 38
Brügmann T, Fladung M (2013) Potentials and limitations of the cross-species transfer of nuclear microsatellite marker in six species belonging to three sections of the genus PopulusL.. Tree Genetics Genomes 9(6):1413-1421, DOI:10.1007/s11295-013-0647-3
- 39
Brügmann T (2011) Entwicklung molekularer Marker zur genetischen Charakterisierung von Genotypen verschiedener Arten der Gattung Populus L.. Hamburg: Universität, 134 p, Hamburg, Univ, Fachber Biologie, Masterarbeit, 2011
- 40
Brügmann T (2009) Optimierung von RNA-Extraktion und cDNA-Synthese aus Quercus robur. Hamburg: Univ, 76 p, Hamburg, Univ, Department Biologie, Bachelorarbeit, 2009
Förderung

Die Nachwuchsforschungsgruppe Genetische Technologien wird vom Bundesministerium für Ernährung und Landwirtschaft über die Fachagentur Nachwachsende Rohstoffe (FNR) finanziell gefördert (Förderkennzeichen 2219NR359).
Das zugrundeliegende Projekt "TreeEdit" ist im Arbeitsbereich Genomforschung angesiedelt.